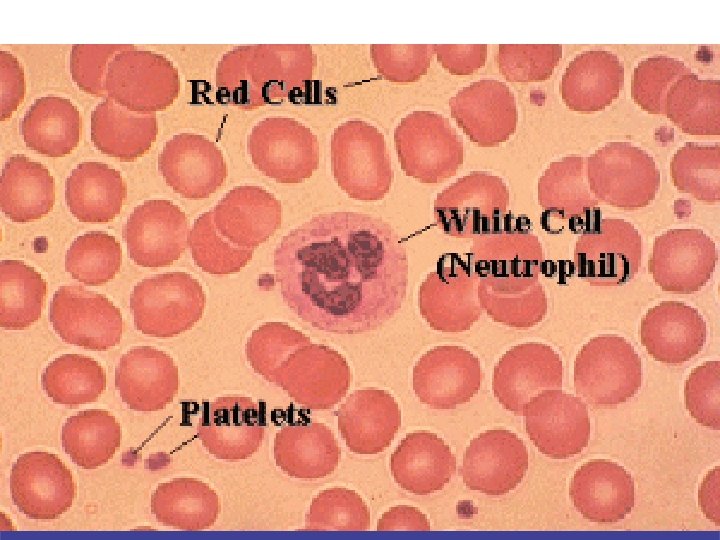

SALIK HZMETLER MESLEK YKSEKOKULU ANESTEZ PROGRAMI ANS 213


















































































- Slides: 82

SAĞLIK HİZMETLERİ MESLEK YÜKSEKOKULU ANESTEZİ PROGRAMI ANS 213 - Sistem Hastalıkları-II Öğr. Gör. Hüsniye AŞIK

KAN HASTALIKLARI Slide 001

Hedefler • • • Anemileri öğrenebilmesi Polisitemia vera hastalığını öğrenebilmesi Lösemileri öğrenebilmesi Trombositopenileri öğrenebilmesi İdiopatik Trombositopenik Purpura (ITP)’yı öğrenebilmesi • Hemofilileri öğrenebilmesi

Kan damarlarında dolaşan kırmızı renkli sıvıya kan adı verilir. Özellikleri ; • Kan sudan daha kalın, daha yapışkan ve daha yoğundur. Kanın viskozitesi sudan daha yoğundur.

• Kanın rengi; arter kanı kırmızıdır, venöz kan ise koyu kırmızıdır. • Kanın PH ‘sı 7, 35 -7, 45 tir, hafif alkalidir. • Kanın ısısı yaklaşık 38 ºC ‘dir. • Ortalama vücut ağırlığının % 8’ini oluşturur. Normal bir insanda 5000 -6000 m. L (5 -6 litre) kadar kan bulunmaktadır.

Kanın Temel Görevleri • Taşıma • Düzenleme • Koruma

Taşıma • Oksijenin akciğerlerden vücut dokularına, vücut dokularında oluşan karbondioksit ve metabolik artıkların karaciğer, böbrek, akciğer ve ter bezleri gibi atılım organlarına taşınması, • Ayrıca besinlerin, hormonların, enzimlerin ve diğer pek çok maddenin çeşitli vücut bölümleri arasında taşınması.

Düzenleme • • Pıhtılaşmanın gerçekleşmesi, Vücut ısısının, Asit-baz dengesinin, Vücut sıvılarındaki su ve elektrolit miktarlarının ayarlanması.

Koruma • Yabancı mikroorganizmalara ve diğer yabancı cisimlere karşı vücut savunmasının gerçekleştirilmesi

Kanın Bileşenleri Kan temel olarak iki bölümden oluşur: – Plazma olarak adlandırılan sıvı bölüm – Şekilli elemanlardan oluşan katı bölüm

Kanın; Plazma Kan hücreleri v % 40 -50'si kan hücrelerinden v % 50 -60‘ı sıvı kısım olan plazmadan meydana gelmektedir.

Kan Hücreleri Alyuvar (Eritrosit) Akyuvar (Lökosit) Kan Pulcukları (Trombosit)

Alyuvar (Eritrosit) • İçlerindeki hemoglobin sayesinde oksijen ve karbondioksit taşınmasında rol oynar. • Kana kırmızı rengini veren hücredir. • 1 mm 3 kanda ortalama 5 milyon alyuvar bulunur. • İnsan vücudunda 120 gün yaşar.

Akyuvar (Lökosit) • Yabancı maddelerle veya hastalık etkenleriyle (virüs, bakteri v. b. ) karşılaştığımızda vücudumuzu koruyan savunma hücreleridir. • Hastalık etkeni vücudumuza girdikten sonra akyuvarlar antikor üretirler. Bu antikorlar hastalık etkenine karşı savaşırlar.

• Birçok çeşidi olmakla birlikte, her çeşidin yaşam süresi farklıdır. • 1 mm 3 kanda ortalama 5000– 10000 kadar akyuvar bulunur.

Kan Pulcukları (Trombosit) • Kanamanın durdurulmasında görevli olan pıhtılaşma hücreleridir. • 1 mm 3 kanda ortalama 250. 000 -500. 000 kadar kan pulcuğu bulunur. • İnsan vücudunda 9 -11 gün yaşarlar.

ALYUVAR (ERİTROSİT) PLAZMA

KAN GRUPLARI Alyuvarlarda (eritrositlerde) bulunan antijen çeşidine göre kan grupları belirlenir 4 ana kan grubu vardır. A B AB O

4 ana kan grubu vardır A B AB O Eritrosit yüzeyinde A antijenini, plazmada B antikorunu taşır. Eritrosit yüzeyinde B antijenini, plazmada A antikorunu taşır. Eritrosit yüzeyinde hem A hem B antijenini taşır, plazmada antikor taşımaz. Eritrosit yüzeyinde antijen taşımaz, ancak plazmada hem A hem B antikorunu taşır.

• Bu antijenlerin yanı sıra Rh(D) faktörü denilen özel bir antijen daha vardır. • Rh faktörünün varlığında Rh pozitif (+), Rh (+), faktörünün yokluğunda Rh negatif (-) olarak tanımlanır.

TANI İŞLEMLERİ Kan hastalıklarının tanısı için genellikle, periferik venlerden alınan venöz kan örnekleri incelenir. En yaygın kullanılan test, kan sayımıdır.

• • • Eritrosit Sayımı Hemoglobin Hematokrit Lökosit Sayımı Periferik Yayma Trombosit Sayımı

• Demir Düzeyi ve Total Demir Bağlama Kapasitesi Testi (60 -90 mg/dl , 250 -420 mg/dl) • Kanama Zamanı • Pıhtılaşma Zamanı • Protrombin Zamanı • Hemoglobin Elektroforezi

ERİTROSİT HASTALIKLARI Eritrositlerin en önemli ve yaygın olan hastalığı “Anemiler” dir.

ANEMİLERİN GENEL SEMPTOMLARI • Ciltte ve mukozalarda renk solukluğu • Gözün beyaz kısmında sarılık (ikter) • Çarpıntı, nefes darlığı, kalpte üfürüm, kalp yetmezliği (şiddetli anemi halinde)

• Dilde yanma, yutma güçlüğü (pernisiyöz anemi ve Fe eksikliği anemilerinde) • Baş ağrısı, baş dönmesi, kulak çınlaması, çabuk yorulma, ellerde uyuşma

Eritrositlerin Yapım Bozukluğuna Bağlı Anemiler Aplastik Anemi (Hipoplastik Anemi) Kemik iliğinin çeşitli nedenlerle baskılanması sonucu; eritrosit, lökosit ve trombositlerin yeterli düzeyde yapılamamasıdır.

Belirti ve bulgular • • Hafif purpura Enfeksiyona yatkınlık İlerleyen halsizlik, yorgunluk Mum rengi gibi solukluk

Tedavisinde ilk yapılacak iş; eğer biliniyorsa etiyolojik ajanı ortadan kaldırmaktır. Etiyolojik ajan bilinmediğinde tedavi semptomatik ve destekleyici önlemlerden ibarettir. -Enfeksiyonları tedavi için antibiyotikler - Kanamaya karşı konsantre trombosit - Anemiye karşı da eritrosit transfüzyonları kullanılır.

Aplastik Aneminin Komplikasyonları • Subaraknoid kanama • Septisemi

Eritrositlerin Yıkımının Artmasına Bağlı Anemiler (Hemolitik Anemiler) Konjenital Hemolitik Anemiler • Herediter Sferositoz Bir eritrosit membran bozukluğudur. Bu bozukluk sonucu hücrenin ozmotik basıncı artmakta, içeriye fazla su girmekte ve hücrenin bikonkav disk şekli bozularak küre şeklini almaktadır.

Belirti ve Bulgular • Hastanın sklerası sarıdır • Splenomegali vardır • Serumda indirekt bilirubin düzeyi hafif artar • İdrarda bilurubin yoktur fakat ürobilinojen artmıştır. Tedavisinde splenektomi yapılır.

Sickle Cell Anemi-Orak Hücreli Anemi Bu hastalıkta eritrositler, hemoglobin S denilen anormal hemoglobin tipi içerirler. Anormallik hemoglobinin “ globin” bölümündedir. Bu hemoglobin tipi oksijeni az olan ortamda kaldığı zaman eritrositler içinde uzun kristaller şeklinde çöker. Bu kristaller hücrenin şeklini uzatır, daha doğrusu yuvarlak bikonkav disk şeklini kaybettirip eritrositlere bir çeşit orak şeklini verir.

Belirti ve Bulgular • Ateş • Sırt, kol ve bacaklarda ağrı • Şiddetli karın ağrısı • Kusma Bu çocuklarda hepatosplenomegali vardır.

Tedavi Orak hücreli aneminin tedavisi semptomatiktir ve iyi bir bakım gerektirir. Hasta enfeksiyonlardan korunur. Anoksi ve dehidratasyonla mücadele edilir.

Talasemiler ( Akdeniz Anemisi) Talasemide hemoglobinin globin ( polipeptik) zincirlerinden birinin sentezi azalır. Talasemiler eksik olan polipeptik zincire göre sınıflandırılır; Beta talasemi, alfa talasemi, gamma talasemi, ve delta talasemi gibi. Talasemilerde genellikle beta zinciri etkilenir ve beta talasemiler sık görülür.

Beta talasemilerin ayrıca 2 tipi vardır; • Homozigot Tipi Talasemi (talasemi majör) • Heterozigot Tipi Talasemi (talasemi minör)


Tedavi • Heterozigot tipi talasemide genellikle tedavi gerekmez. • Homozigot tipi talasemide ciddi anemi tablosu görüldüğünden tedaviye gerek vardır. Talaseminin halen uygulanan tek tedavisi kan transfüzyonudur.

Beslenme Bozukluğuna Bağlı Anemiler Demir Eksikliği Anemisi Demir eksikliği anemisi; yetersiz demir alınması, alınan demirin emilememesi yada fazla kaybı sonucu gelişen mikrositik, hipokromik tipte kronik anemi şeklidir.

Belirti ve bulgular • • Yorgunluk, halsizlik Çarpıntı, efor dispnesi Sersemlik İştahsızlık Dil yanması Kabızlık Tırnakların ince olup çok çabuk kırılması Tırnakların düzleşmesi veya konkavlaşarak kaşık tırnak şeklini alması • Serum demiri düşük olup (genellikle %40 mikrondan az) serum toplam demir bağlama kapasitesi yüksektir (%400 mikrogram veya daha fazla)

Tedavide amaç demir eksikliğine yol açan nedeni bulup ortadan kaldırmak ve eksik demiri tamamlamaktır Erişkinlerde emilimi kolay olan demir sülfat günde 3 defa 200 -300 mg ağızdan verilir.

Megaloblastik Anemiler Megaloblastik anemilerin çoğu B 12 vitamini ve folik asit eksikliğinden ileri gelir. Her iki vitaminin eksikliği eritropoezis süresince olgunlaşma yetersizliğine yol açar.


Pernisiyöz Anemi ( B 12 Yetersizliği) Pernisiyöz anemi; B 12 vitamini eksikliğine bağlı makrositik bir anemidir. İntrensik faktör yetersizliği olan pernisiyöz anemide esas bozukluk, mide mukozasının normal salgı yapamayacak biçimde atrofik olmasıdır.

Belirti ve bulgular - Çabuk yorulma Nefes darlığı Parestezi Dil yanması Dil kırmızı renkte olup üzerinde papillalar silinmiş, düz ve kaygan bir hal almıştır.

Tedavi Pernisiyöz anemili hastanın tedavisi ömür boyu belirli aralıklarla B 12 verilmesinden ibarettir. Hastaya balık, et, süt ve yumurta gibi demir ve proteinden zengin diyet alması önerilir.

Folik Asit Eksikliğine Bağlı Anemi Bu tür anemi folik asit yetersizliğine bağlı olarak gelişir ve oldukça yaygındır. Folik asit eksikliği anemisi; yoksulluk ve bilgisizlik, kronik hastalıklar ve kronik alkolizm gibi nedenlerle yetersiz beslenen kişilerde gelişir.

Belirti ve bulgular • Sindirim sistemi bozuklukları • Mukozalarda atrofi ( - Atrofik glosit - bağırsak villuslarında atrofi… gibi)

Tedavide amaç; hem folik asit yetersizliğini tamamlamak hemde nedeni bulup ortada kaldırmaktır. Folik asit eksikliğinde ağızdan günde 1 mg folik asit verilmesi genellikle yeterli olup bir hafta içinde tedaviye cevap alınır. Genellikle hastalara 1 -2 aylık ağızdan folik asit tedavisi yapıldıktan sonra ilaç kesilerek folik asit bakımından zengin bir diyete geçilir.

Hastaya yeşil sebzeler, portakal/limon ve karaciğer gibi folik asit içeren besinler alması önerilir.

POLİSİTEMİLER Polisitemi, kandaki eritrosit sayısının ve hemoglobin konsantrasyonunun artması olup eritrositler 8 -12 milyona, hemoglobin konsantrasyonu ise 18 -25 gr/100 ml kadar yükselebilir.

Polisitemia Vera Polisitemia vera kemik iliğinin kronik proliferatif bir hastalığı olup organizmada eritrosit kitlesinin devamlı artmasıyla karakterizedir.

Belirti ve bulgular • Hastanın yüzü ve ekstremiteleri vişne kırmızısı rengindedir, gözdesi normal renktedir • Baş ağrısı, baş dönmesi • Halsizlik • Geçici körlük, diplopi • Kulak çınlaması

Komplikasyonları • Trombozlar (buna bağlı olarak pıhtılaşma faktörlerinin harcanması çesitli kanamalara neden olur. Bu nedenle hastalarda ekimoz, hematom, epistaksis, hemoptizi, hematemez ve melena görülebilir. ) • Böbrek taşları

Tedavide temel amaç; 1 - Kan volümünün ve viskozitesinin azaltılması 2 - Kemik iliği aktivitesinin azaltılması

• Kan volümünü azaltmak için flebetomi yapılır. • Eritropoezisi kontrol altına alabilmek için radyoaktif fosfor (P 32) yada sitostatikler kullanılır.

LÖSEMİLER Lösemi lökosit ve benzeri hücrelerin anormal ve kontrolsüz çoğalması, kemik iliği, çoğunlukla kan ve diğer dokuların bu hücrelerle infiltrasyonu ile karakterize, etiyolojisi bilinmeyen ve çoğunlukla fatal seyirli bir hastalık grubuna verilen genel addır.

Lösemi Tipleri Hematopoietik (kan yapımını etkileyen) malignansiler, kaynaklandığı lenfoid ya da miyoloid olarak kök hücreye göre sınıflandırılır. Ayrıca, semptomlarının ortaya çıkış zamanı ve hastalığın seyrine göre akut yada kronik olarak nitelendirilir. Bunlar: § AKUT MYELOBLASTİK LÖSEMİ (AML) § KRONİK MYELOSİTİK LÖSEMİ (KML) § AKUT LENFOBLASTİK LÖSEMİ (ALL) § KRONİK LENFOSİTİK LÖSEMİ (KLL)

Hastalığın Seyri • Akut lösemide semptomlar birkaç hafta içinde aniden başlar. • Akut lösemiler çok hızlı ilerler, tedavi edilmediğinde birkaç hafta yada ay içinde ölüm gerçekleşebilir.

Etiyolojisi Lösemilerin nedeni tam olarak bilinmemektedir. Ancak viral hastalık patogenizi ya da genetik etkilenme olabileceğine ilişkin göstergelerden bahsedilmektedir. Kemik iliği, radyasyon ve benzeri melphen gibi bazı kimyasal maddelere maruz kalması sonucu harabiyete uğrar.

TANI İŞLEMLERİ Tam kansayımı yapılır. Trombositopeni ve eritropeni vardır. Periferik kanın morfolojik değerlendirilmesi yapılır. Kemik iliği aspirasyonunda olgunlaşmamış blast hücreler vardır.

BELİRTİ VE BULGULAR Ateş ve enfeksiyon nötropeniden, halsizlik ve yorgunluk anemiden, kanamaya eğilim trombositopeniden kaynaklanmaktadır. Blastlar, dişeti, karaciğer, dalak ve deriye infiltre olur. Lösemik hücrelerin infiltrasyonuna bağlı olarak karaciğer ve dalak büyümesi nedeniyle ağrı, dişetlerinde hipertrofi, kemik iliği genişlemesi ile ilgili kemik ve eklem ağrısı görülür.

TEDAVİ Akut lösemilerin tedavisinde acil yoğun kemoterapi yapılır. Başlangıç kemoterapisine genellikle indüksiyon denir ve bu aşamada tam remisyon hedeflenmektedir.

• İndüksiyon tedavisinin amacı lösemik hücreleri yok etmeyi sağlamaktır. • AML de en sık kullanılan kemoterapik ajan, IDARUBİSİN ve ARA-C dir. • ALL de en sık kullanılan kemoterapik ajanlar, VİNCRİSTİNE, PREDNİSONE, DAUNORUBİCİNE, CYCLOPHOSPHAMİDE ve L-ASPARAGİNASE’dır.

• Destek tedavi olarak kan ürünleri (eritrosit trombosit ve taze donmuş plazma) transfüzyonu yapılır.

• Ancak bu yoğun tedaviye rağmen, remisyon süresi fazla uzun sürmemektedir. Hastaların % 70’inde relaps (hastalığın tekrarı) görülmektedir. En uzun remisyon ortalama 5 yıl kadardır. • Akut lösemili hastalara uygulanan diğer bir tedavi yöntemi kemik iliği transplantasyonudur. Bu tedavi yönteminin amacı; hasta kemik iliği yerine normal kemik iliği konmasıdır.

Trombositopeniler Trombositlerin sayısının az olmasına denir. Trombosit sayısı; 50. 000 -150. 000/mm 3 olduğunda hiçbir klinik belirti görülmez, 20. 000 -50. 000/mm 3 olduğunda kolay morarma, ameliyatlardan sonra uzun süren kanamalar, 20. 000/mm 3’den daha düşük olduğunda ise spontan ekimozlar, GİS ve diğer sistemlere bağlı ciddi kanamalar ortaya çıkar.

Trombositopeni yapan hastalıklar fizyolojik olarak 3 gruba ayrılır; • Trombosit yapım azlığı • Trombosit dağılım bozuklukları • Trombositlerin yıkımının artışı (ITP)

c) Trombositlerin yıkımının artışı (ITP) İdiopatik trombositopenik purpurada (ITP) trombosit yıkım artışı mevcuttur. Trombositlerin yıkımı; - İmmünolojik mekanizmalar - Nonimmünolojik mekanizmalar ile olabilir.

İdiopatik Trombositopenik Purpura (ITP) Trombositlerin immünolojik nedenlerle yıkımının arttığı en sık rastlanan hastalık idiopatik trombositopenik purpuradır. ITP’nin en önemli özelliği; trombositlerin yaşam sürelerinin 1 -3 gün yada daha az bir zamana inmiş olmasıdır.

Belirti ve Bulgular § Deri ve mukozalarda § § gelişen purpuralar Burun kanaması, diş eti kanamaları, kadınlarda period arasında kanama Akut vakalarda hafif ateş

Tedavi ve Hemşirelik Bakımı • Kortikosteroidler kullanılır • Splenektomi yapılır • Destekleyici tedavi olarak kan transfüzyonu uygulanabilir

PIHTILAŞMA BOZUKLUKLARI HEMOFİLİLER Hemofililer 3 gruba ayrılır; 1 - Hemofili A (Klasik Hemofili) 2 - Hemofili B (Christmas Hastalığı) 3 - Von Willebrand Hastalığı

Hemofili A (Faktör VIII Eksikliği) Uzun zamandır bilinen bir hastalıktır ve sıklıkla ailenin erkek çocuklarında görülür. X kromozomu ile geçen bir hastalıktır.

Belirti ve Bulguları § Spontan kanamalar (Sıklıkla hemartroz oluşur) § Eklem ağrıları § Ciddi vakalarda deri altı, kas içi § § § kanamaları, hematüri, epistaksis, kafa içi kanamalar, … vb kanamalar görülür Faktör VIII normalin %20 -25 altındadır Pıhtılaşma zamanı uzar PTZ (Protrombin zamanı) ve kanama zamanı normaldir

Tedavide eksik olan faktörün yerine konması, en yararlı yaklaşımdır. Hastaya fibrinojen, F. VIII ve K vitaminine bağlı olan faktörleri ( F. II, VII, IX, X) içeren konsantre solüsyonlar verilir.

Hemofili A’nın küçük kanamalarında; taze yada taze dondurulmuş plazma 2 -4 gün süre ile 10 -15 ml/kg dozda 12 saatte bir verilir.

Büyük kanamalarda ise 30 ml/kg ile yükleme yapılır. 10 -14 gün süre ile 15 ml/kg dozda tedaviye devam edilir.

Hemofili B’nin küçük kanamasında 30 ml/kg ile yükleme yapılır. 2 -4 gün süre ile 12 saatte bir 7 ml/kg ile devam edilir. Büyük kanamalarda ise; 60 ml/kg ile yükleme yapılır. 10 -14 gün süre ile 7 ml/kg dozda devam edilir.

Teşekkürler…